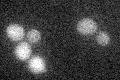
YGL170C
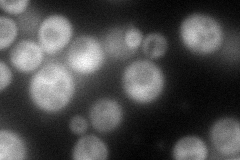
YGL170C
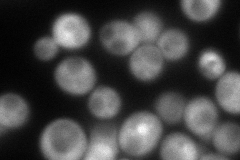
YGL170C
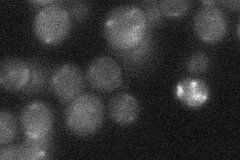
YGL170C
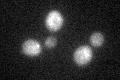
YGL170C

View description
Component of the meiotic outer plaque of the spindle pole body, involved in modifying the meiotic outer plaque that is required prior to prospore membrane formation
Localization:
Intensity:
Fold change:
Significance:
-
C’ GFP library in SD
below threshold16.75 -
N' NOP1pr-GFP in SD
cytosol98.4678 -
N' TEF2pr-mCherry in SD
cytosol119.394 -
N' NATIVEpr-GFP in SD
below threshold20.3566 -
N' TEF2pr-VC and Cyto-VN in SD

punctate42.9937 -
C’ GFP library in SD+DTT
cytosol17.21.02No -
C’ GFP library in SD+H2O2

cytosol17.511.04No -
C’ GFP library in Starvation Media

cytosol15.580.92No -
C’ GFP library on the background of Pup2-DaMP

below threshold -
C’ GFP library on the background of CCT mutant

below threshold19.33581.15342No
